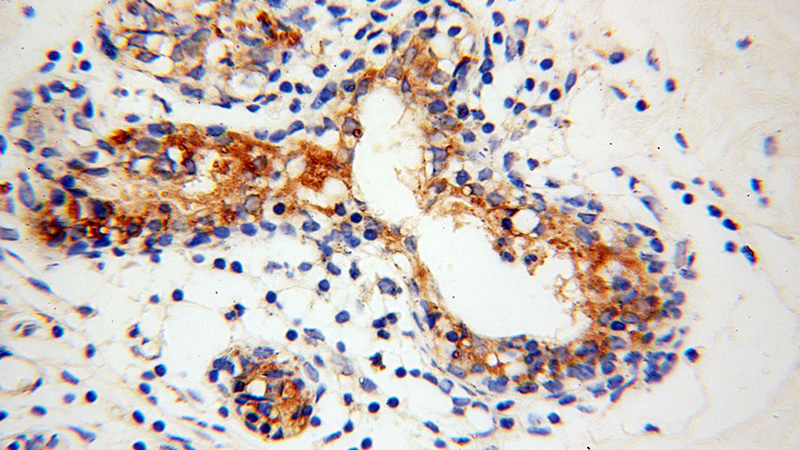
Immunohistochemical of paraffin-embedded human colon cancer using Catalog No:111317(GUSB antibody) at dilution of 1:50 (under 40x lens)

-
Product Name
GUSB antibody
- Documents
-
Description
GUSB Rabbit Polyclonal antibody. Positive WB detected in mouse liver tissue, HL-60 cells, mouse heart tissue. Positive IHC detected in human colon cancer tissue. Observed molecular weight by Western-blot: 78kd
-
Tested applications
ELISA, WB, IHC
-
Species reactivity
Human,Mouse,Rat; other species not tested.
-
Alternative names
Beta G1 antibody; Beta glucuronidase antibody; FLJ39445 antibody; glucuronidase antibody; beta antibody; GUSB antibody; MPS7 antibody
-
Isotype
Rabbit IgG
-
Preparation
This antibody was obtained by immunization of GUSB recombinant protein (Accession Number: NM_000181). Purification method: Antigen affinity purified.
-
Clonality
Polyclonal
-
Formulation
PBS with 0.02% sodium azide and 50% glycerol pH 7.3.
-
Storage instructions
Store at -20℃. DO NOT ALIQUOT
-
Applications
Recommended Dilution:
WB: 1:200-1:2000
IHC: 1:20-1:200
-
Validations

mouse liver tissue were subjected to SDS PAGE followed by western blot with Catalog No:111317(GUSB antibody) at dilution of 1:500

Immunohistochemical of paraffin-embedded human colon cancer using Catalog No:111317(GUSB antibody) at dilution of 1:50 (under 10x lens)
Immunohistochemical of paraffin-embedded human colon cancer using Catalog No:111317(GUSB antibody) at dilution of 1:50 (under 40x lens)
-
Background
The GUSB gene encodes beta-glucuronidase, a lysosomal hydrolase involved in the stepwise degradation of glucuronic acid-containing glycosaminoglycans.It is a tetrameric glycoprotein composed of identical subunits.GUSB plays an important role in the degradation of dermatan and keratan sulfates.It has two isoforms.
-
References
- Wang AL, Lukas TJ, Yuan M, Du N, Handa JT, Neufeld AH. Changes in retinal pigment epithelium related to cigarette smoke: possible relevance to smoking as a risk factor for age-related macular degeneration. PloS one. 4(4):e5304. 2009.
- Ishisaka A, Kawabata K, Miki S. Mitochondrial dysfunction leads to deconjugation of quercetin glucuronides in inflammatory macrophages. PloS one. 8(11):e80843. 2013.
Related Products / Services
Please note: All products are "FOR RESEARCH USE ONLY AND ARE NOT INTENDED FOR DIAGNOSTIC OR THERAPEUTIC USE"
